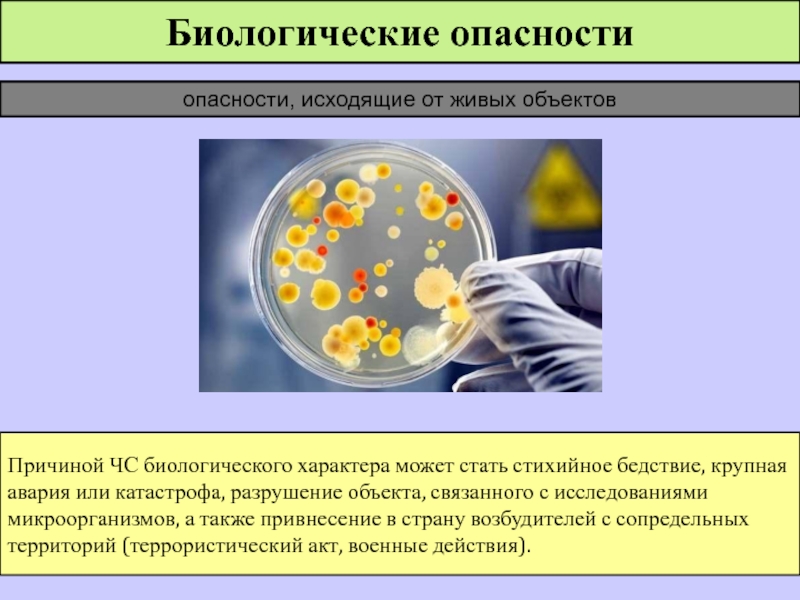

Разделы презентаций
- Разное
- Английский язык
- Астрономия
- Алгебра
- Биология
- География
- Геометрия
- Детские презентации
- Информатика
- История
- Литература
- Математика
- Медицина
- Менеджмент
- Музыка
- МХК
- Немецкий язык
- ОБЖ
- Обществознание
- Окружающий мир
- Педагогика
- Русский язык
- Технология
- Физика
- Философия
- Химия
- Шаблоны, картинки для презентаций
- Экология
- Экономика
- Юриспруденция
ЧРЕЗВЫЧАЙНЫЕ СИТУАЦИИ ТЕХНОГЕННОГО ХАРАКТЕРА 1
Содержание
- 1. ЧРЕЗВЫЧАЙНЫЕ СИТУАЦИИ ТЕХНОГЕННОГО ХАРАКТЕРА 1
- 2. Задание на СРС:Учебник «Безопасность жизнедеятельности» Сапронов Ю.Г.Стр. 11 - 12
- 3. Слайд 3
- 4. КЛАССИФИКАЦИЯ ЧС ПО ПРОИСХОЖДЕНИЮ (ТЕХНОГЕННЫЕ ЧС)Техногенной
- 5. КЛАССИФИКАЦИЯ ЧС ПО
- 6. Авария на транспорте - это повреждение транспортного
- 7. Автомобильные аварии превышение скоростиОколо 75 % всех
- 8. Меры безопасностиприжаться к рулевой колонке, а на
- 9. Причины аварий на ж/д транспортеПриродные причины аварий
- 10. закрепиться и препятствовать своему перемещению вперед или
- 11. Причины аварий на воздушном транспортеразрушения отдельных конструкций
- 12. Правила безопасностипри возможности выбора садиться в кресло,
- 13. Причины аварий (катастроф) на водном транспортеПриродные причины:ураганы,
- 14. Предварительные меры защитызапоминание дороги из своей каюты
- 15. КЛАССИФИКАЦИЯ ЧС ПО
- 16. КЛАССИФИКАЦИЯ ЧС ПО
- 17. Химически опасное вещество (ХОВ) - это простое
- 18. Группы ХОВ по негативному воздействию :с преимущественно
- 19. Слайд 19
- 20. КЛАССИФИКАЦИЯ ЧС ПО
- 21. КЛАССИФИКАЦИЯ ЧС ПО
- 22. Биологические опасности опасности, исходящие от живых объектовПричиной ЧС
- 23. вдыхание зараженного воздухаИсточники зараженияпопадание микробов или токсинов
- 24. Средства защиты населениявакцинно-сывороточные препараты антибиотикиспециальная и экстренная
- 25. 6. Внезапное обрушение зданий,
- 26. Обычно чем большая степень разрушения сооружения,
- 27. КЛАССИФИКАЦИЯ ЧС ПО
- 28. 9. Аварии на очистных сооружениях: аварии на
- 29. КЛАССИФИКАЦИЯ ЧС ПО
- 30. ГДОО - гидротехнические сооружения или естественные образования,
- 31. - чрезвычайное событие, связанное с выводом из
- 32. Основным средством защиты населения от катастрофического затопления
- 33. Уровни опасности
- 34. Скачать презентанцию
Слайды и текст этой презентации
Слайд 4КЛАССИФИКАЦИЯ ЧС ПО ПРОИСХОЖДЕНИЮ
(ТЕХНОГЕННЫЕ ЧС)
Техногенной является ЧС происхождение которой
связано с производственной деятельностью человека на объектах техносферы.
Возникает в следствие аварий с самопроизвольным выходом в окружающее пространство вещества или энергии.Слайд 5
КЛАССИФИКАЦИЯ ЧС ПО ПРОИСХОЖДЕНИЮ
(ТЕХНОГЕННЫЕ ЧС)
1. Транспортные аварии
(катастрофы):
аварии поездов;
аварии речных и морских судов;
авиакатастрофы;
аварии
(катастрофы) на автодорогах (крупные автомобильные); аварии транспорта на мостах, железнодорожных переездах, в тоннелях;
аварии на магистральных трубопроводах.
Слайд 6Авария на транспорте - это повреждение транспортного средства.
Аварии (катастрофы):
автомобильные
Катастрофа
– это авария с трагическими последствиями, связанными с гибелью людей.
на
ж/д транспортена авиационном транспорте
на водном транспорте
Слайд 7Автомобильные аварии
превышение скорости
Около 75 % всех аварий на автомобильном
транспорте происходит из-за нарушения водителями правил дорожного движения.
Причины аварий
на автомобильном транспорте:игнорирование дорожных знаков
выезд на полосу встречного движения
управление автомобилем в нетрезвом состоянии
плохие дороги (главным образом скользкие)
технические неисправности (на первом месте – тормоза, на втором – рулевое управление, на третьем – колеса и шины).
Слайд 8Меры безопасности
прижаться к рулевой колонке, а на месте пассажира Вы
должны закрыть голову руками и завалиться набок.
сгруппироваться и закрыть
голову рукаминапрячь все мышцы до предела
не препятствовать своему перемещению вперед.
если Вы сидите на водительском месте - вжаться в сиденье спиной и, напрягая все мышцы, упереться руками в рулевое колесо
если Вы в качестве пассажира сидите на переднем сиденье - упереться в «торпеду», а если сзади – то в переднее сиденье.
Не покидать машину до ее остановки
шансов выжить в автомобиле в 10 раз больше, чем при выпрыгивании из нее.
Если аварию предотвратить невозможно
Во время аварии
Если не пристегнулись ремнем безопасности
Слайд 9Причины аварий на ж/д транспорте
Природные причины аварий и катастроф:
землетрясения
наводнения
обвалы, оползни,
сели, снежные лавины
ураганы
природные пожары
Причины, связанные с деятельностью человека:
неисправности железнодорожного пути
неисправность
поезданеисправности средств сигнализации
ошибки диспетчеров
невнимательность и халатность машинистов
Слайд 10закрепиться и препятствовать своему перемещению вперед или броскам в стороны
для
этого во время удара, толчка, возникших в результате аварии, постарайтесь
ухватиться за неподвижные части вагона или сгруппируйтесь и прикройте голову во избежание травмМеры безопасности
При крушении или экстренном торможении
крепко держаться руками и упираться ногами в стену, верхнюю полку и т.п.
При переворачивании вагона
после приобретения устойчивости, наметить пути выхода из вагона
выбираться через окна, вытаскивая на руках детей и пострадавших
Если вагон опрокинут или поврежден
отойти от вагонов на 30-50 метров, чтобы не попасть под шаговое напряжение
В случае обрыва проводов контактной сети
Слайд 11Причины аварий на воздушном транспорте
разрушения отдельных конструкций самолёта
отказ двигателей
нарушение работы
систем управления, электропитания, связи, пилотирования
недостаток топлива
перебои в жизнеобеспечении экипажа и
пассажировСлайд 12Правила безопасности
при возможности выбора садиться в кресло, которое расположено рядом
с выходом и, по возможности, ближе к середине или хвосту
самолетапоинтересоваться, где располагаются выходы (основные и аварийные) на Вашем самолете и как они открываются
при взлете и посадке следить за тем, чтобы Ваш ремень безопасности был плотно затянут
быть внимательным к командам и сигналам, которые передаются по микрофону, световому табло или бортпроводницами
Декомпрессия – это разряжение воздуха в салоне самолёта при нарушении его герметичности.
Слайд 13Причины аварий (катастроф) на водном транспорте
Природные причины:
ураганы, штормы
туманы
дрейфующие льды (айсберги)
По
вине людей:
неверные действия капитанов, лоцманов и членов экипажа
ошибки при проектировании
и строительстве кораблейизнос оборудования корабля
Слайд 14Предварительные меры защиты
запоминание дороги из своей каюты к спасательным средствам
на верхнюю палубу
изучение инструкции по действиям в аварийных ситуациях, правил
пользования спасательными средствамипроведение тренировок по использованию спасательных средств
Слайд 15
КЛАССИФИКАЦИЯ ЧС ПО ПРОИСХОЖДЕНИЮ
(ТЕХНОГЕННЫЕ ЧС)
2. Пожары,
взрывы, угрозы взрывов:
пожары (взрывы) в зданиях, на коммуникациях и технологическом
оборудовании промышленных объектов; на транспортепожары (взрывы) на объектах добычи, переработки и хранения легковоспламеняющихся, горючих и взрывчатых веществ;
пожары (взрывы) в шахтах, подземных и горных выработках,
пожары (взрывы) на химически опасных объектах;
пожары (взрывы) на радиационно опасных объектах;
обнаружение неразорвавшихся боеприпасов;
утрата взрывчатых веществ (боеприпасов).
Слайд 16
КЛАССИФИКАЦИЯ ЧС ПО ПРОИСХОЖДЕНИЮ
(ТЕХНОГЕННЫЕ ЧС)
3. Аварии
с выбросом (угрозой выброса) химически опасных веществ:
аварии с выбросом сильно
действующих ядовитых веществ (СДЯВ) при их производстве, переработке, хранении (захоронении); аварии на транспорте с выбросом (угрозой выброса) СДЯВ;
образование и распространение СДЯВ в процессе химических реакций, начавшихся в результате аварии;
аварии с химическими боеприпасами;
утрата источников ХОВ.
Слайд 17Химически опасное вещество (ХОВ)
- это простое вещество или химическое
соединение, выброс которого в окружающую среду может привести к образованию
очага поражения, а также загрязнению окружающей природной среды.Аварийно химически опасное вещество (АХОВ)
- это вещество ингаляционного действия, при выбросе или разливе которых может произойти массовое поражение людей и заражение окружающей природной среды.
Слайд 18Группы ХОВ по негативному воздействию :
с преимущественно удушающим действием (хлор,
фосген, хлорпикрин );
общеядовитого действия (окись углерода, цианистый водород );
удушающего и
общеядовитого действия (амил, оксид азота, сернистый ангидрид, фтористый водород);нейтропного действия, т.е. влияющие на генерацию, проведение и передачу нервных импульсов (сероуглерод, тетраэтилсвинец );
удушающего и нейтропного действия (аммиак, гентил, гидрозин );
метаболические -нарушающие обмен веществ в организме (окись этилена, дихлорэтан, диоксин ).
Слайд 20
КЛАССИФИКАЦИЯ ЧС ПО ПРОИСХОЖДЕНИЮ
(ТЕХНОГЕННЫЕ ЧС)
4. Аварии
с выбросом (угрозой выброса) радиоактивных веществ:
аварии на АЭС, атомных энергетических
установках производственного и исследовательского назначения; аварии на предприятиях ядерно- топливного цикла;
аварии транспортных средств и космических аппаратов с ядерными установками или грузом РВ на борту;
аварии при промышленных и испытательных ядерных взрывах с выбросом (угрозой выброса) РВ;
Слайд 21
КЛАССИФИКАЦИЯ ЧС ПО ПРОИСХОЖДЕНИЮ
(ТЕХНОГЕННЫЕ ЧС)
5. Аварии
с выбросом (угрозой выброса) биологически опасных веществ (БОВ):
аварии на
предприятиях и в научно-исследовательских учреждениях (лабораториях); аварии на транспорте;
утрата БОВ.
Слайд 22Биологические опасности
опасности, исходящие от живых объектов
Причиной ЧС биологического характера может
стать стихийное бедствие, крупная авария или катастрофа, разрушение объекта, связанного
с исследованиями микроорганизмов, а также привнесение в страну возбудителей с сопредельных территорий (террористический акт, военные действия).Слайд 23вдыхание зараженного воздуха
Источники заражения
попадание микробов или токсинов на слизистую оболочку
и поврежденную кожу
употребление в пищу зараженных продуктов питания и воды
укусы
зараженных насекомых и клещейсоприкосновение с зараженными предметами
ранения осколками боеприпасов, снаряженных бактериальными (биологическими) средствами
непосредственное общение с больными людьми (животными)
Слайд 24Средства защиты населения
вакцинно-сывороточные препараты
антибиотики
специальная и экстренная профилактика инфекционных болезней
средства
индивидуальной и коллективной защиты
химические вещества, используемые для обезвреживания возбудителей инфекционных
заболеванийобсервация и карантин
санитарная обработка населения
дезинфекция зараженных объектов
дезинсекция и дератизация
Слайд 25 6. Внезапное обрушение зданий, сооружений
обрушение элементов
транспортных коммуникаций;
обрушение производственных зданий и сооружений;
обрушение зданий и
сооружений жилого, социально-бытового и культурного назначения.
КЛАССИФИКАЦИЯ ЧС ПО ПРОИСХОЖДЕНИЮ
(ТЕХНОГЕННЫЕ ЧС)
Слайд 26
Обычно чем большая степень разрушения сооружения, тем большее количество
травмированных с тяжелыми степенями.
Поражающие факторы при обрушениях:
прямое воздействия ударной волны
косвенное
воздействие обломками конструкций, осколками стекла и т.д. ожоги, отравления в зонах задымления
неполное сгорание продуктов горения в завалах
травматическая асфиксия вследствие резкого и длительного сдавления грудной клетки у находящихся под завалами
Слайд 27
КЛАССИФИКАЦИЯ ЧС ПО ПРОИСХОЖДЕНИЮ
(ТЕХНОГЕННЫЕ ЧС)
7. Аварии на электроэнергетических системах:
аварии
на электростанциях с долговременным перерывом электроснабжения всех потребителей;
аварии на
электроэнергетических системах (сетях); выход из строя транспортных электроконтактных сетей.
8. Аварии на системах коммунального обеспечения:
- аварии на канализационных системах с массовым выбросом загрязняющих веществ;
аварии на тепловых сетях (системах горячего водоснабжения);
аварии в системах снабжения населения питьевой водой;
аварии на коммунальных газопроводах.
Слайд 289. Аварии на очистных сооружениях:
аварии на очистных сооружениях сточных
вод промышленных предприятий с массовым выбросом загрязняющих веществ;
аварии на
очистных сооружениях промышленных газов с массовым выбросом загрязняющих веществ.
КЛАССИФИКАЦИЯ ЧС ПО ПРОИСХОЖДЕНИЮ
(ТЕХНОГЕННЫЕ ЧС)
Слайд 29
КЛАССИФИКАЦИЯ ЧС ПО ПРОИСХОЖДЕНИЮ
(ТЕХНОГЕННЫЕ ЧС)
10. Гидродинамические
аварии:
- прорывы плотин (дамб, шлюзов, перемычек и др.) с
образованием волн прорыва и катастрофических затоплений, повлекшие смыв плодородных почв или отложение наносов на обширных территориях. Слайд 30ГДОО - гидротехнические сооружения или естественные образования, создающее разницу уровней
воды до и после этого объекта
Гидродинамически опасные объекты (ГДОО)
Плотины
- гидротехнические сооружения (искусственные плотины) или природные образования (естественные плотины), ограничивающие сток, создающие водохранилища и разницу уровней воды по руслу рекиВодохранилища – водоем, в котором скапливается и сохраняется вода. Водохранилища могут быть долговременными (гидротехнические сооружения) и кратковременными (действие сил природы)
Запруда – простейшая плотина, обычно в виде насыпи
Основные гидротехнические
сооружения
Слайд 31- чрезвычайное событие, связанное с выводом из строя (разрушением) гидротехнического
сооружения или его части и неуправляемым перемещением больших масс воды,
несущих разрушения и затопление обширных территорийдействие сил природы (землетрясения, ураганы, размывы плотин);
воздействие человека;
конструктивные дефекты или ошибки проектирования.
Причины разрушениея (прорыва) гидротехнических сооружений:
Основное следствие прорыва плотины - катастрофическое затопление местности, заключающееся в стремительном затоплении волной прорыва нижерасположенной местности и возникновением наводнения
Гидродинамическая авария